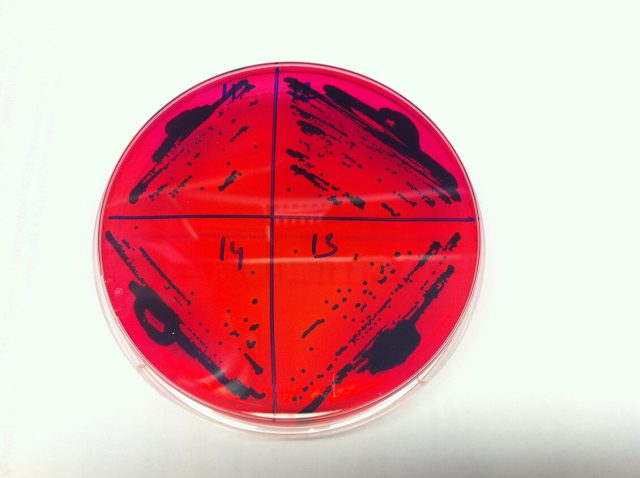

Kesehatan
Pencangkokan Tinja Diberhentikan Setelah Kematian Seorang Pasien
Untuk mengobati infeksi clostridium difficile, para ahli kesehatan di AS yang tergabung dalam Infectious Diseases Society of America (IDSA) telah mengusulkan sebuah pedoman berupa penanaman bakteri bermanfaat yang dikenal sebagai mikrobioma yang bersarang di usus orang sehat. Namun, sebuah kasus kematian yang baru ditemukan sebagai dampak dari penularan bakteri berbahaya, mendorong Badan Pengawas Obat dan Makanan Amerika Serikat (FDA) untuk segera...
Ditemukan Bakteri Salmonella yang Kebal Terhadap Semua Jenis Antibiotik di AS
Para peneliti dari North Carolina State University telah menemukan sebuah gen yang membuat Salmonella menjadi resisten (kebal) terhadap semua jenis antibiotik dari sampel yang diambil dari seorang pasien di AS. Penemuan ini adalah bukti pertama yang mengindikasikan bahwa gen mcr-3.1 telah memasuki wilayah AS dari Asia. Ada lebih dari 2.500 tipe Salmonella yang telah diketahui. Di AS, Samonella enetica 4,,12:i:-ST34...
Pola Konsumsi Makanan Tinggi Kalori Ternyata Bisa “Memakan” Otak Anda
Para peneliti dan ahli kesehatan dari ANU (Australian National University) menemukan bahwa rata-rata konsumsi makanan orang-orang di masa kini setiap hari memiliki kandungan kalori yang jauh lebih tinggi dibanding 50 tahun yang lalu, yaitu dengan kelebihan kalori yang setara dengan satu porsi besar burger setiap hari. Kenyataan ini sangat mengkhawatirkan, karena berdasarkan hasil penelitian, gaya hidup dengan pola makan...
Enam jari per tangan
Polydactyly adalah kondisi luar biasa dari seseorang yang dilahirkan dengan lebih dari lima jari tangan atau kaki. Dalam sebuah studi kasus yang dipublikasikan di Nature Communications, para peneliti dari University of Freiburg, Imperial College London, Rumah Sakit Universitas Lausanne, dan EPFL untuk pertama kalinya memeriksa keterampilan motorik dan area otak sensorimotor pada orang dengan polydactyly. Hasil menunjukkan bahwa jari ekstra...
Sistem Saraf Dapat Mengirimkan Informasi Lintas Generasi
Sebuah studi menemukan mekanisme yang ditunjukkan oleh nematoda yang memungkinkan sel-sel sistem saraf untuk berkomunikasi dengan sel germinal/benih (seperti sprema/ovum) yang ditransmisikan ke generasi selanjutnya. Penelitian ini mengidentifikasi mode di mana neuron mengirimkan pesan ke generasi mendatang. Nematoda, cacing yang ditemukan di hampir semua habitat lingkungan, adalah salah satu model organisme yang paling sering digunakan dalam penelitian, karena bereproduksi dengan cepat dan genomnya mengandung jumlah...
Terapi Gelombang Radio Terbukti Efektif Melawan Sel Kanker Hati
Sebuah terapi baru untuk penyembuhan kanker menggunakan gelombang radio non-termal yang dapat diarahkan telah ditunjukkan berhasil memblokir pertumbuhan sel kanker hati yang menyebar di seluruh tubuh tanpa merusak sel sehat, menurut sebuah penelitian yang dilakukan oleh para ilmuwan di Wake Forest School of Medicine, bagian dari Wake Forest Baptist Health . Temuan penelitian ini diterbitkan dalam jurnal EBioMedicine. Dengan menggunakan pemodelan hewan,...
Fakta Terbaru: Buah dan Sayur Beku Lebih Tinggi Nutrisinya Dibandingkan Buah dan Sayur Segar
Semua orang sudah menyadari bahwa demi kesehatan, konsumsi buah dan sayur sangatlah dianjurkan. Tetapi, apa yang terjadi apabila buah-buahan favorit Anda ternyata tidak sedang dalam musimnya, atau sayur-sayuran dalam daftar belanja Anda ternyata akan dimakan dalam beberapa hari mendatang? Mungkin buah dan sayur beku akan membantu Anda. Mengkonsumsi buah beku memungkinkan Anda untuk menikmati buah favorit Anda ketika tidak sedang dalam...
Ditemukan Senyawa Baru Untuk Bakteri yang Tahan Antibiotik
Para ilmuwan telah menemukan senyawa baru yang dapat memvisualisasikan serta memusnahkan super bakteri yang tahan terhadap antibiotik. Tim peneliti dari University of Sheffield dan Rutherford Appleton Laboratory (RAL) yang dipimpin oleh Profesor Jim Thomas, sedang menguji senyawa baru yang dikembangkan terhadap bakteri gram negatif yang tahan terhadap antibiotik, termasuk bakteri patogen E. coli. Strain bakteri gram negatif dapat menyebabkan infeksi termasuk pneumonia, infeksi saluran kemih dan infeksi...
Musik Membantu Mengembangkan Otak Bayi Prematur
Meskipun kemajuan dalam pengobatan bayi prematur saat ini telah memberikan mereka kesempatan hidup yang baik, namun anak-anak ini berisiko tinggi mengalami gangguan neuropsikologis. Sebagian besar akan bertahan hidup, tetapi setengahnya kemudian akan mengembangkan gangguan perkembangan saraf, termasuk kesulitan belajar, gangguan perhatian atau emosional. Untuk membantu otak bayi prematur yang rapuh ini berkembang sebaik mungkin selain lingkungan perawatan intensif yang penuh...
Alat Sederhana Pendeteksi Hormon Stress dalam Keringat, Darah, Urin, dan Air Liur
Stress seringkali disebut sebagai “the silent killer” atau pembunuh senyap tanpa suara karena secara diam-diam dan misterius bisa menyebabkan berbagai efek bagi kesehatan, mulai dari penyakit jantung hingga mempengaruhi kesehatan mental. Saat ini, para peneliti di University of Cincinnati tengah mengembangkan sebuah bentuk pengujian terbaru yang bisa dengan mudah mendeteksi keberadaan hormon stress dari keringat, darah, urin ataupun air liur....